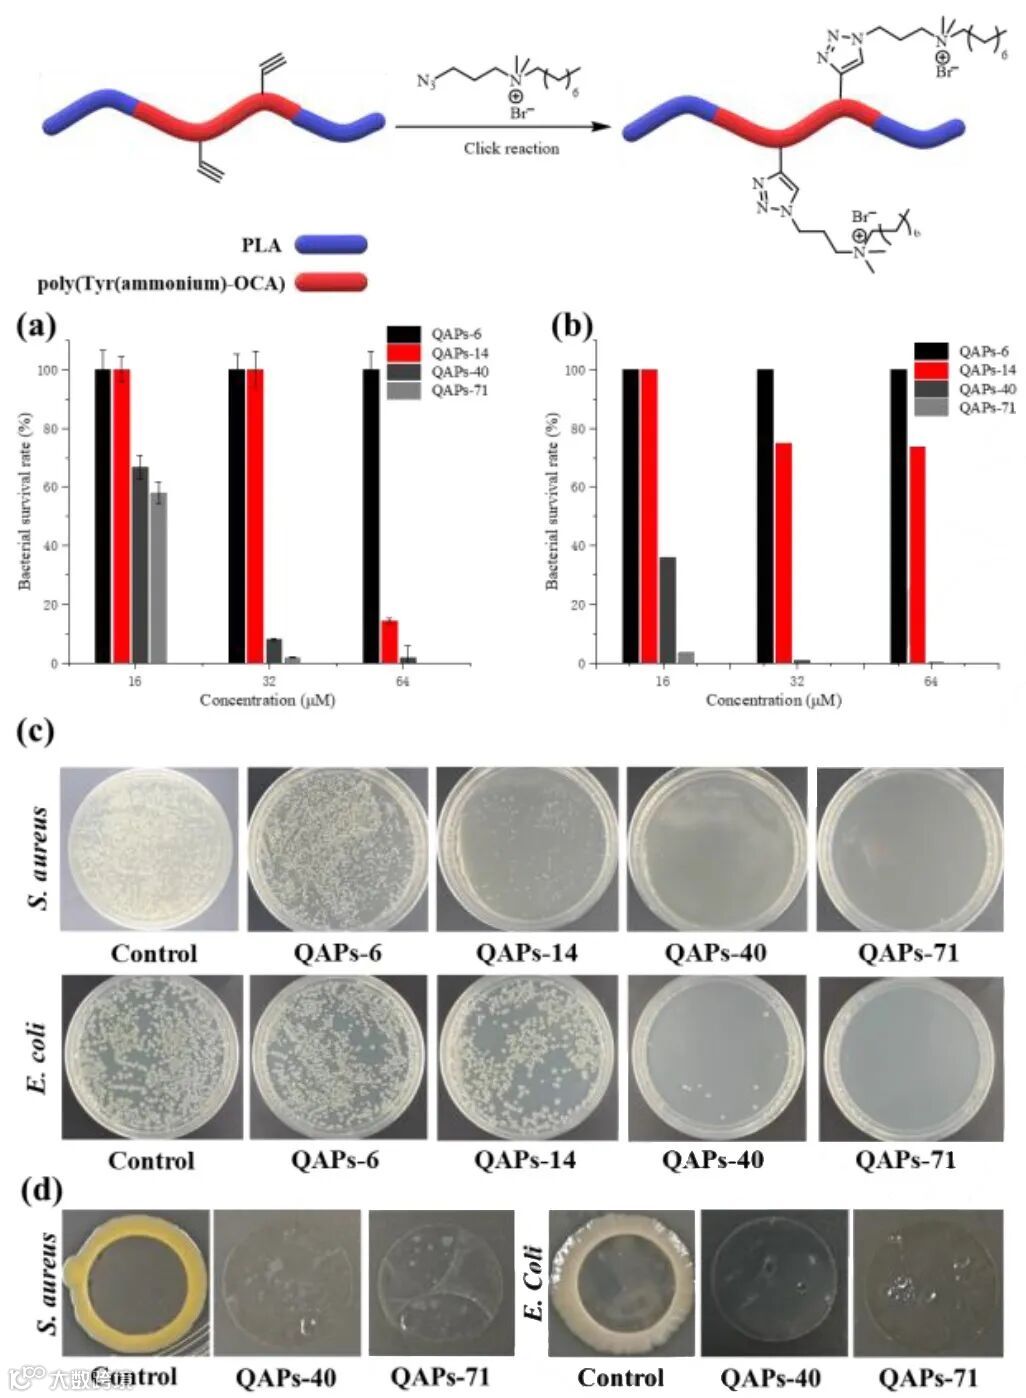

脂肪族聚酯由于其优异的生物相容性和可降解性引起了科研和工业领域的广泛关注。聚α-羟基酸(PAHA)是一类非常重要的聚酯材料。以聚乳酸(PLA)为例,可降解性的PLA可由丙交酯开环聚合制备,在医药、农业和工业领域具有重要的应用价值。然而,这种聚合物固有的疏水性和脆性极大地限制了其应用范围。因此,开发具有功能化的聚乳酸材料将具有广阔的应用前景。
近日,中国科学院长春应用化学研究所陈学思院士和庞烜研究员利用SalenMn(III)Cl催化剂实现了丙交酯(LA)与1,3-二氧戊环-2,4-二酮(OCA)的可控开关聚合反应,制备出功能化嵌段型可降解聚酯。相关内容发表在Angew. Chem. Int. Ed.(DOI: 10.1002/anie.202017088)上。
OCA的聚合过程相较于LA而言,吉布斯自由能更低,并且聚合过程中所释放的CO2也会引起反应过程中熵和焓的变化。而SalenMn(III)Cl催化剂又具有十分特殊的性质。其与环氧烷烃共存后,会先生成SalenMnOR活性种,这种活性种可以快速地聚合LA或者己内酯;而这种活性种又能够快速吸收CO2,得到SalenMnOCOR,这种结构难以聚合LA,但可以快速聚合OCA。作者猜想,能否利用OCA聚合所产生的少量CO2实现这种可控开关聚合反应,进而制备出嵌段型聚合物呢?

(图片来源:Angew. Chem. Int. Ed.)
作者首先利用SalenMn(III)Cl催化剂单独催化LA与OCA的聚合反应,这两种过程都能够迅速进行,制备出高分子量、窄分布的聚合物。但作者发现,将两者混合后,仅能够聚合OCA。即便OCA已被消耗完全,LA也难以实现聚合反应,这意味着外在的CO2能够极大地抑制LA的聚合过程。那么,能否利用OCA聚合过程中释放的痕量CO2实现这种开关聚合反应呢?作者进行了接下来的实验。
首先催化剂与LA混合,加入环氧环己烷作为溶剂,4 h后,得到分子量为6.4 kg/mol、窄分布的PLA;而后加入OCA,此时,LA聚合反应几乎停止,在之后的一个小时里,LA仅聚合了2%,可以认为SalenMnOR活性种已完全转变为SalenMnOCOR;接下来OCA参与聚合反应,OCA反应完全后,除去体系中的CO2,LA聚合过程又能够继续进行。GPC测试曲线也证实在反应过程中,聚合物的分子量逐渐增大,而分子量分布不变,得到嵌段型聚合物。利用上述方法,作者还进行了三步开关聚合过程,成功制备出五嵌段聚合物。原位ATR-IR曲线也能够清晰地表征聚合过程中开/关过程。反应初期,LA参与聚合,PLA含量逐渐增加;OCA加入后,LA聚合停止,同时CO2浓度增大,OCA含量降低;待OCA反应完全后,抽走残余CO2,LA聚合继续进行,PLA再次生成,得到三嵌段聚合物。

(图片来源:Angew. Chem. Int. Ed.)

(图片来源:Angew. Chem. Int. Ed.)
作者对多种OCA单体进行了聚合过程研究,发现其都能够很好地实现开/关聚合反应,而且所制备的聚合物经过后处理后,具有一定的抑菌能力,在生物领域具有很好的应用前景。
(图片来源:Angew. Chem. Int. Ed.)
作者利用SalenMnCl催化剂实现了OCA与LA的可控开/关聚合反应,为PLA功能化进程开辟了一条新路。
原文链接:
https://onlinelibrary.wiley.com/doi/10.1002/anie.202017088
相关进展
免责声明:部分资料来源于网络,转载的目的在于传递更多信息及分享,并不意味着赞同其观点或证实其真实性,也不构成其他建议。仅提供交流平台,不为其版权负责。如涉及侵权,请联系我们及时修改或删除。邮箱:info@polymer.cn
诚邀投稿
欢迎专家学者提供稿件(论文、项目介绍、新技术、学术交流、单位新闻、参会信息、招聘招生等)至info@polymer.cn,并请注明详细联系信息。高分子科技®会及时推送,并同时发布在中国聚合物网上。
欢迎加入微信群 为满足高分子产学研各界同仁的要求,陆续开通了包括高分子专家学者群在内的几十个专项交流群,也包括高分子产业技术、企业家、博士、研究生、媒体期刊会展协会等群,全覆盖高分子产业或领域。目前汇聚了国内外高校科研院所及企业研发中心的上万名顶尖的专家学者、技术人员及企业家。
申请入群,请先加审核微信号PolymerChina (或长按下方二维码),并请一定注明:高分子+姓名+单位+职称(或学位)+领域(或行业),否则不予受理,资格经过审核后入相关专业群。
点
这里“阅读原文”,查看更多


